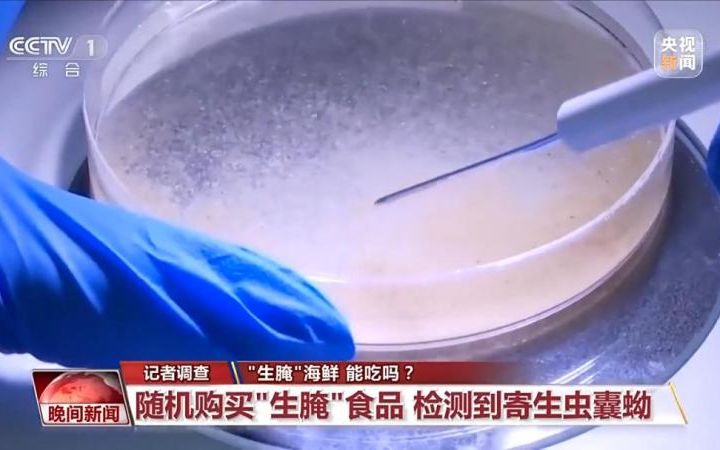

夏日炎炎,在不少人眼里,生鱼片、醉虾、呛蟹等“生腌”海鲜都是美味。

今天,不少有关“生腌”的话题冲上热搜
所谓“生腌”,就是把鱼、虾、蟹等海鲜或河鲜,用酒、姜、蒜等调料腌制,再冷藏或冷冻制作而成。虽然美味,但最近媒体也报道了不少人食用后感染寄生虫的案例。“生腌”海鲜能吃吗?白酒、芥末等能杀死食材里的寄生虫吗?有什么平时常见的误区?一起来看
误区一
海鱼比淡水鱼更安全
记者通过网购、饭店和菜市场采购的方式,购买了醉蟹、醉虾等生食,送往专业实验室进行检测。最后,实验人员在一份醉虾产品中检测到了寄生虫的囊蚴。囊蚴是吸虫的幼虫,进入人体后会吸附在肠壁上,长成后仍会留在体内甚至入侵脏器。
江苏省寄生虫病防治研究所副研究员戴洋表示,生食中我国最常见的寄生虫就是淡水鱼里面的肝吸虫和海鱼里面的异尖线虫。
华支睾吸虫又称肝吸虫,是中国淡水鱼中最常见的一种致病寄生虫。如果食用了被肝吸虫感染的生鱼片,虫体可能会寄生在人体胆管、胆囊内,引起胆管炎、胆囊炎、胆结石等。专家特别强调,认为海鱼比淡水鱼更安全是不对的。
首都医科大学附属北京天坛医院普外科主任医师郑建伟表示,华支睾吸虫来自生食的海鲜和淡水鱼,其引起肝硬化、肝癌的风险非常高。
误区二
高浓度酒能杀死细菌
还有一种误区是认为,可以通过白酒、芥末等调料杀死食物里的寄生虫。
首都医科大学附属北京天坛医院普外科主任医师郑建伟表示,很多人用酒、醋或者其他材料腌制,认为达到了这种消毒标准。尤其是有一些从河里或海里捞上来以后还明显有污染的,用了高浓度酒腌制,但高浓度酒与医用高浓度酒精差别很大,并且浸泡时间、深度都不达标,因此,这种所谓的生腌食品还是有很大风险的。
购买生鲜食品
选择正规渠道
我国生熟食品的国家标准不一样,对生鲜食品的检验检测更加严格。如果一定要食用或制作生腌食品,要在正规渠道购买达标的生鲜食材。
水产品里有寄生虫
如何安全吃海鲜

广告
广告
广告